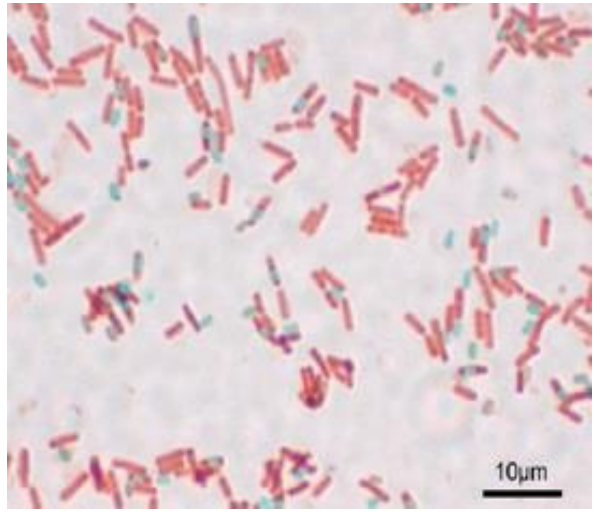
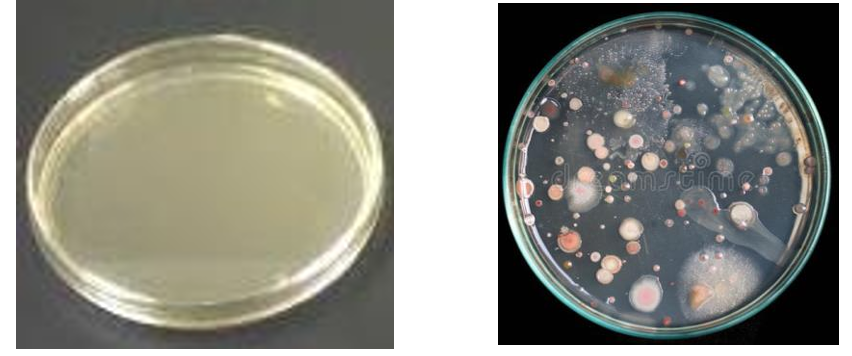
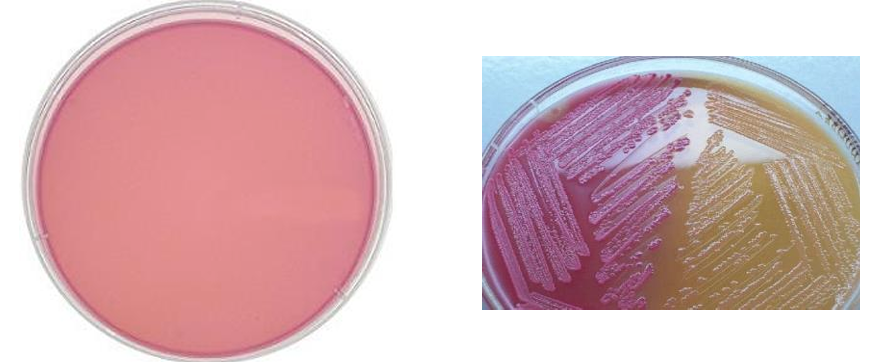
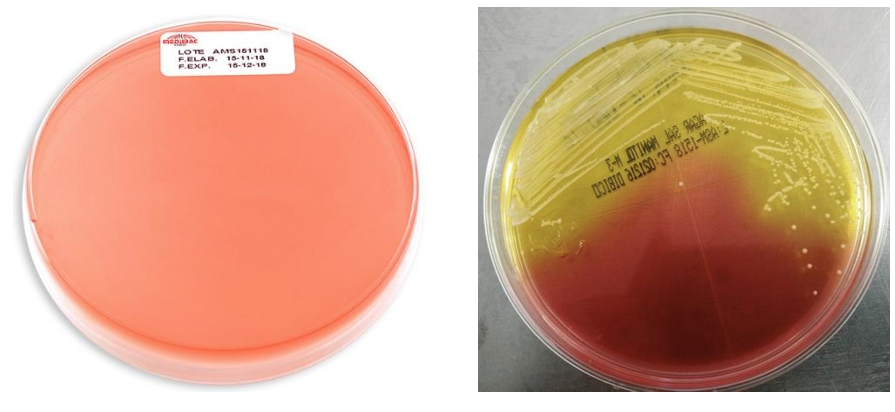
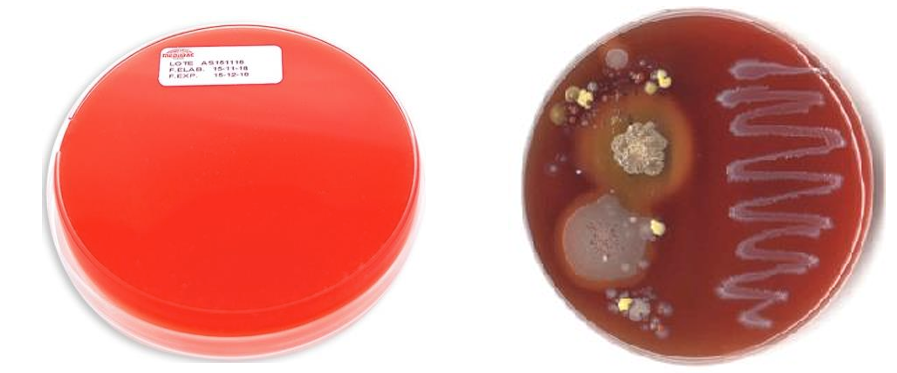
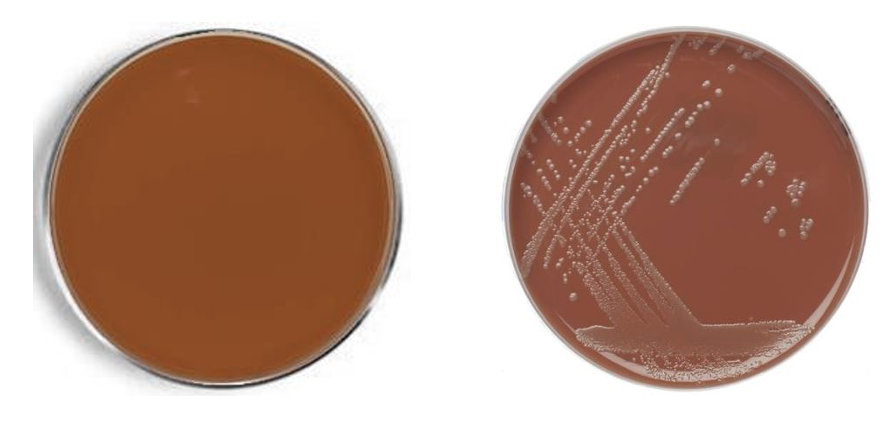
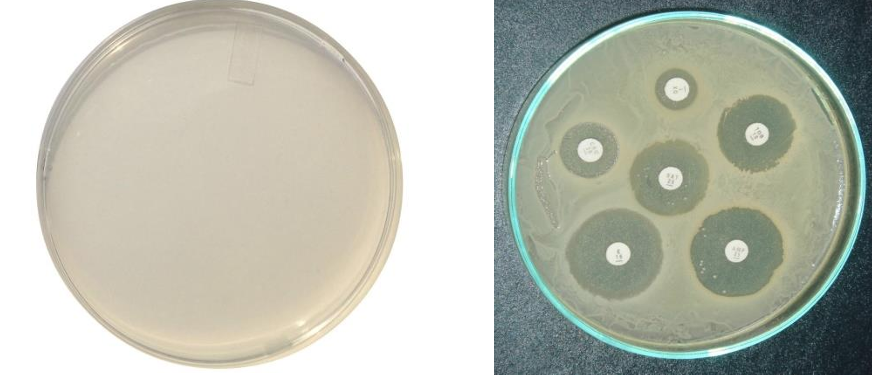
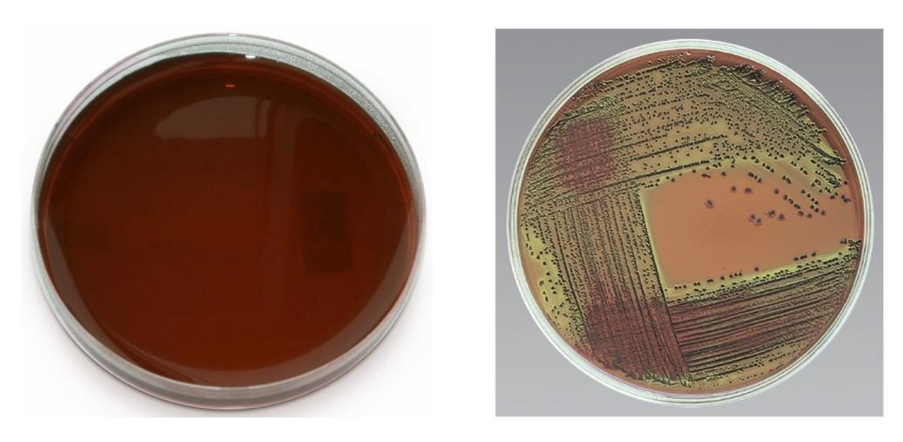

Pasos de la tinción de gram: (10)
- Gota de agua + bacteria (diluir) = fijar con mechero
- Tinción CRISTAL VIOLETA (1min)
- Enguajar
- Tinción YODO (1min)
- Enguajar
- Limpiar ALCOHOL ETÍLICO 95% (10-15 seg)
- enguajar
- Tinción SAFRANINA (1min)
- enguajar
- secar

¿Qué tiñe la tinción de gram?
Pared de peptidoglicanos de las bacterias
¿Qué tiñe la tinción de wirtz-conklin?
Endoesporas bacterianas
Pasos de la tinción de wirtz-conklin: (7)
- fijar muestra
- tinción VERDE MALAQUITA 5%
- colocar papel filtro y secar a mechero (5 min)
- enguajar
- tinción SAFRANINA 1% (1 min)
- enjuagar
- seca
Color de las endoesporas en Wirtz-conklin:
verde (malaquita)
Color de las células en wirtz-conklin:
Rosa (safranina)
Función del agar nutritivo
bacterias que no requieren de condiciones nutricionales especiales (amplia gama)
Composición del agar nutritivo (1)
Caldo nutritivo (cerebro, corazón, etc)
Función del agar MacConkey: (selectivo y diferencial)
SELECTIVO: aislamiento de enterobacterias y BGN entéricos
DIFERENCIAL: fermentadoras / no fermentadoras de lactosa (rojo neutro = rojo)
Composición del agar MacConkey (4)
Sales biliares/Cristal violeta
lactosa
Cloruro de sodio
(rojo neutro = rojo)
Bacterias que crecen en Agar McConkey y fermentación: (6)
Fermentadoras (ROJO): E. coli (intensa), Kliebsiella pneumoniae (mucosas), enterobacterias.
NO fermentadoras (AMARILLO): Salmonella, shigella y proteus.
Función del agar sal y manitol: (selectivo y diferencial)
SELECTIVO: Staphilococcos spp.
DIFERENCIAL: (Fermentación de manitol)
* PATOGÉNICOS: colonias amarillas
* NO patogénicos: colonias rosas
Composición del agar sal y manitol: (3)
Manitol: fuente de carbono
Sal: inhibe crecimiento bacteriano
(rojo fenol = amarillo)
Función del agar sangre de carnero: (DIFERENCIAL)
Medio enriquecido; Permite visualizar actividad HEMOLÍTICA
(alfa, beta, gamma)
Composición del agar sangre: (2)
Base enriquecida + 5% sangre
(peptonas, aa, vit, extracto de carne, NaCl, agar)
Bacterias que muestran cada uno de los tipos hemolíticos: (7)
Alfa hemólisis = S. Pneumoniae, S. viridans
Beta hemólisis = S. agalactie, S. pyogens, S. aureus
Gamma hemólisis = Enterococco fecalis y staph coagulasa negativos
Función agar chocolate:
Medio enriquecido; Crecimiento de organismos difíciles o exigentes
Composición del agar chocolate: (2)
Eritrocitos lisados (calentados) + Factor X y V de la coagulación.
Función agar Muller Hinton:
Medio enriquecido (almidón y carne de res), sensibilidad y resistencia a Ab de bacterias (antibiograma).
Composición del agar Muller Hinton: (3)
Extracto de carne de res
Hidrolizado de caseína
Almidon y agar
Función del agar EMB (Eosin Methylene Blue) (selectivo y diferencial) (5)
SELECTIVO: enterobacterias (BGN)
DIFERENCIAL: fermentadores y no fermentadores de lactosa
Fuertes = verde metálico
Medio = violeta
Débil = transpartente
Composición del agar EMB: (3)
Eosina y azul de metileno (inhiben BGP) + lactosa
Bacterias que crecen en EMB y fermentación: (Fuerte, media, débil)
Fermentación FUERTE (Verde metálico) = E. coli
Fermentación MEDIA (Violeta) = klebsiella pneumoniae y enterobacter
Fermentación DÉBIL (Transparentes) = Salmonella, shigella y proteus.
Función del agar XLD: (diferencial y selectivo)
SELECTIVO: salmonella, shigella y escherichia
DIFERENCIAL: (rojo fenol = amarillo)
rosa pálido = NO fermentadoras
negro = producen ácido sulfhídrico
amarillo = fermentadoras de lactosa

















